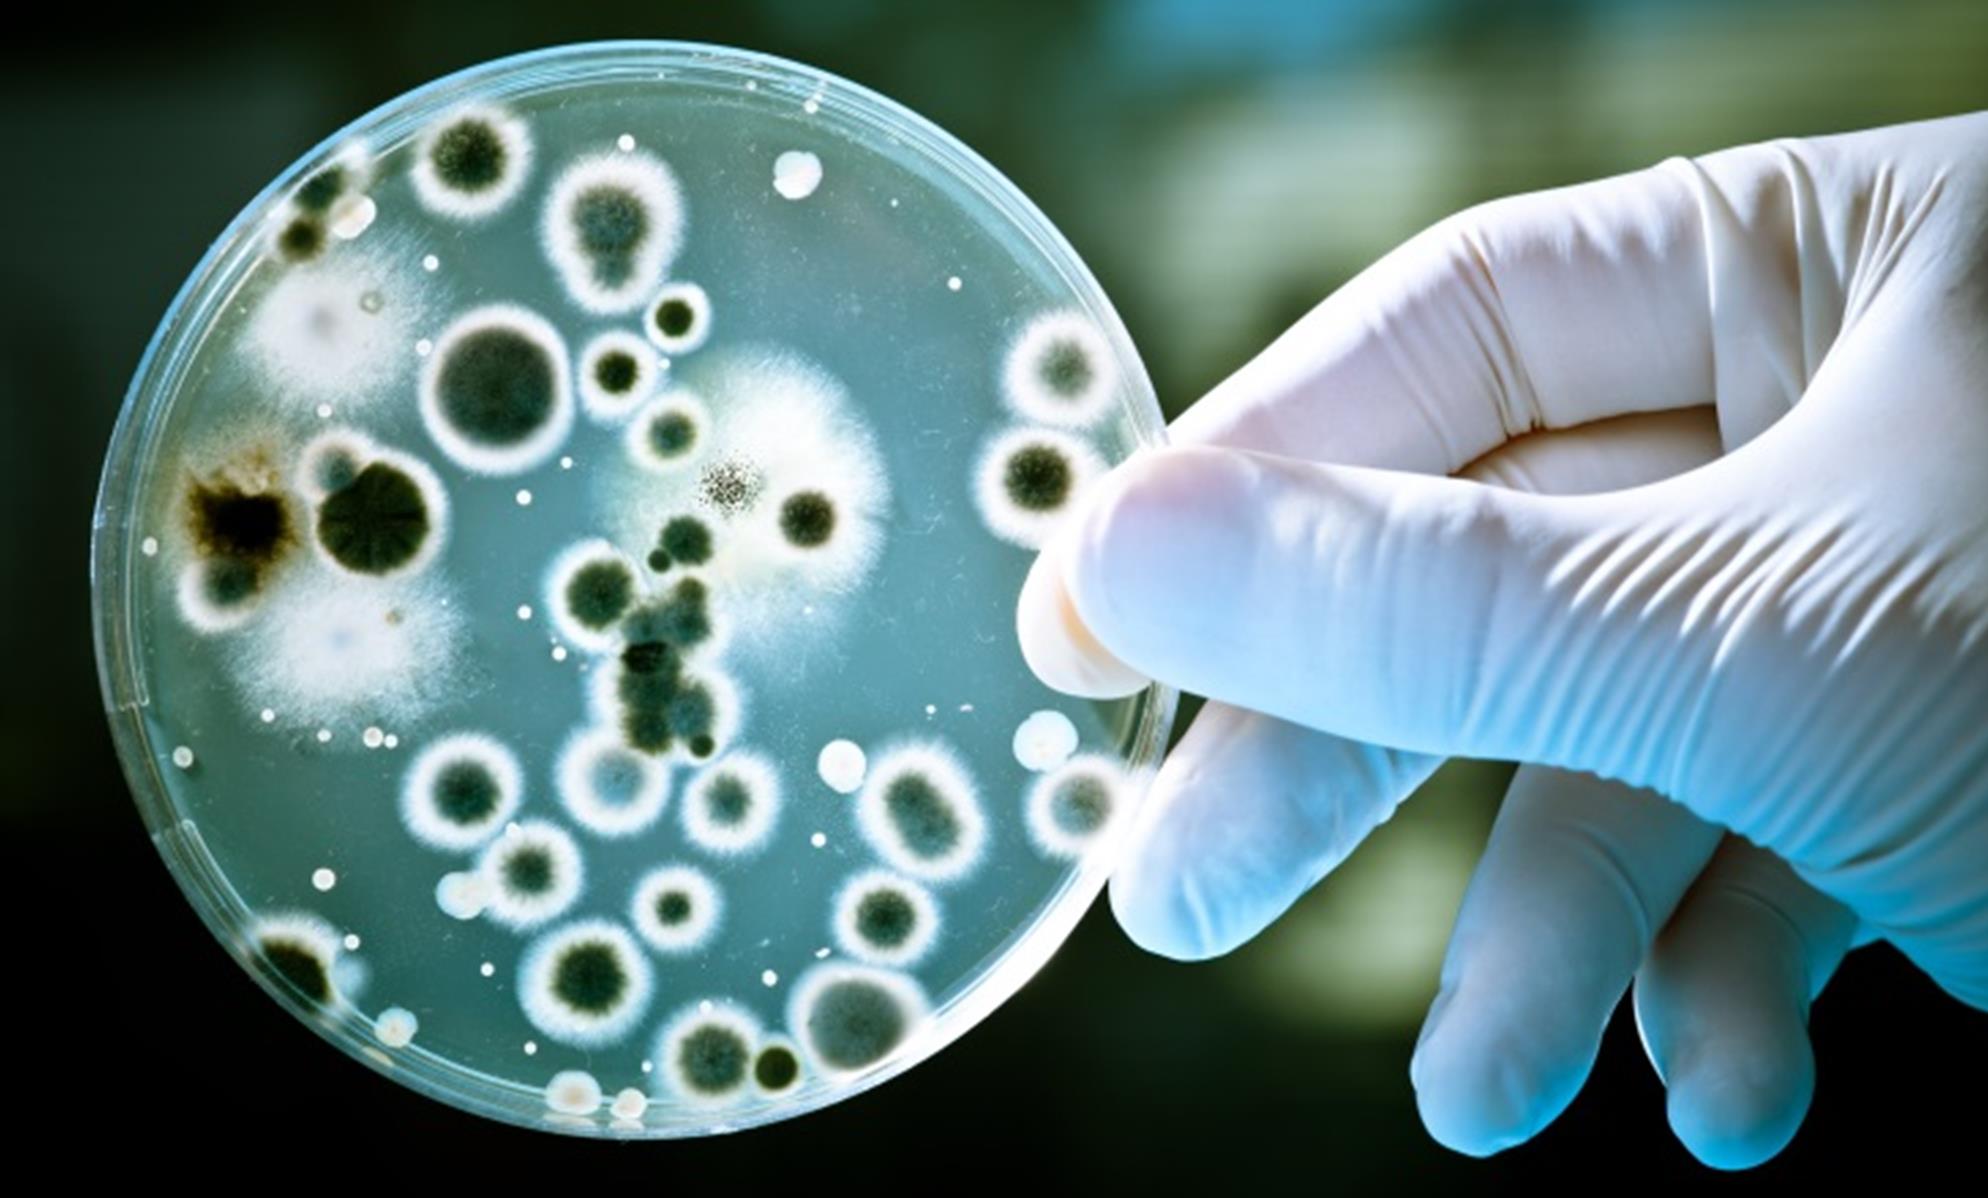

La Biotecnología aprovecha la capacidad natural que tienen los microorganismos de poder alimentarse de estos compuestos orgánicos.
España es el principal productor y exportador mundial de aceite de oliva, con una superficie dedicada a la oliva de 2,5 millones de hectáreas aproximadamente. Lo que representa más de la mitad de la producción de la UE y el 40% de la mundial. Por lo que el sector oleícola confiere un enorme patrimonio económico, cultural y ambiental al país.
España es el principal productor y exportador mundial de aceite de oliva, con una superficie dedicada a la oliva de 2,5 millones de hectáreas aproximadamente. Lo que representa más de la mitad de la producción de la UE y el 40% de la mundial. Por lo que el sector oleícola confiere un enorme patrimonio económico, cultural y ambiental al país.
En los últimos años, se está prestando gran atención a la contaminación microbiana, ya que su incidencia se ha incrementado sustancialmente. El proceso empleado en la producción del combustible afecta a la composición final del producto, la cual determina la mayor o menor susceptibilidad del producto a ser atacado por microorganismos.
En los últimos años, se está prestando gran atención a la contaminación microbiana, ya que su incidencia se ha incrementado sustancialmente. El proceso empleado en la producción del combustible afecta a la composición final del producto, la cual determina la mayor o menor susceptibilidad del producto a ser atacado por microorganismos.
En los últimos años, se está prestando gran atención a la contaminación microbiana, ya que su incidencia se ha incrementado sustancialmente. El proceso empleado en la producción del combustible afecta a la composición final del producto, la cual determina la mayor o menor susceptibilidad del producto a ser atacado por microorganismos.